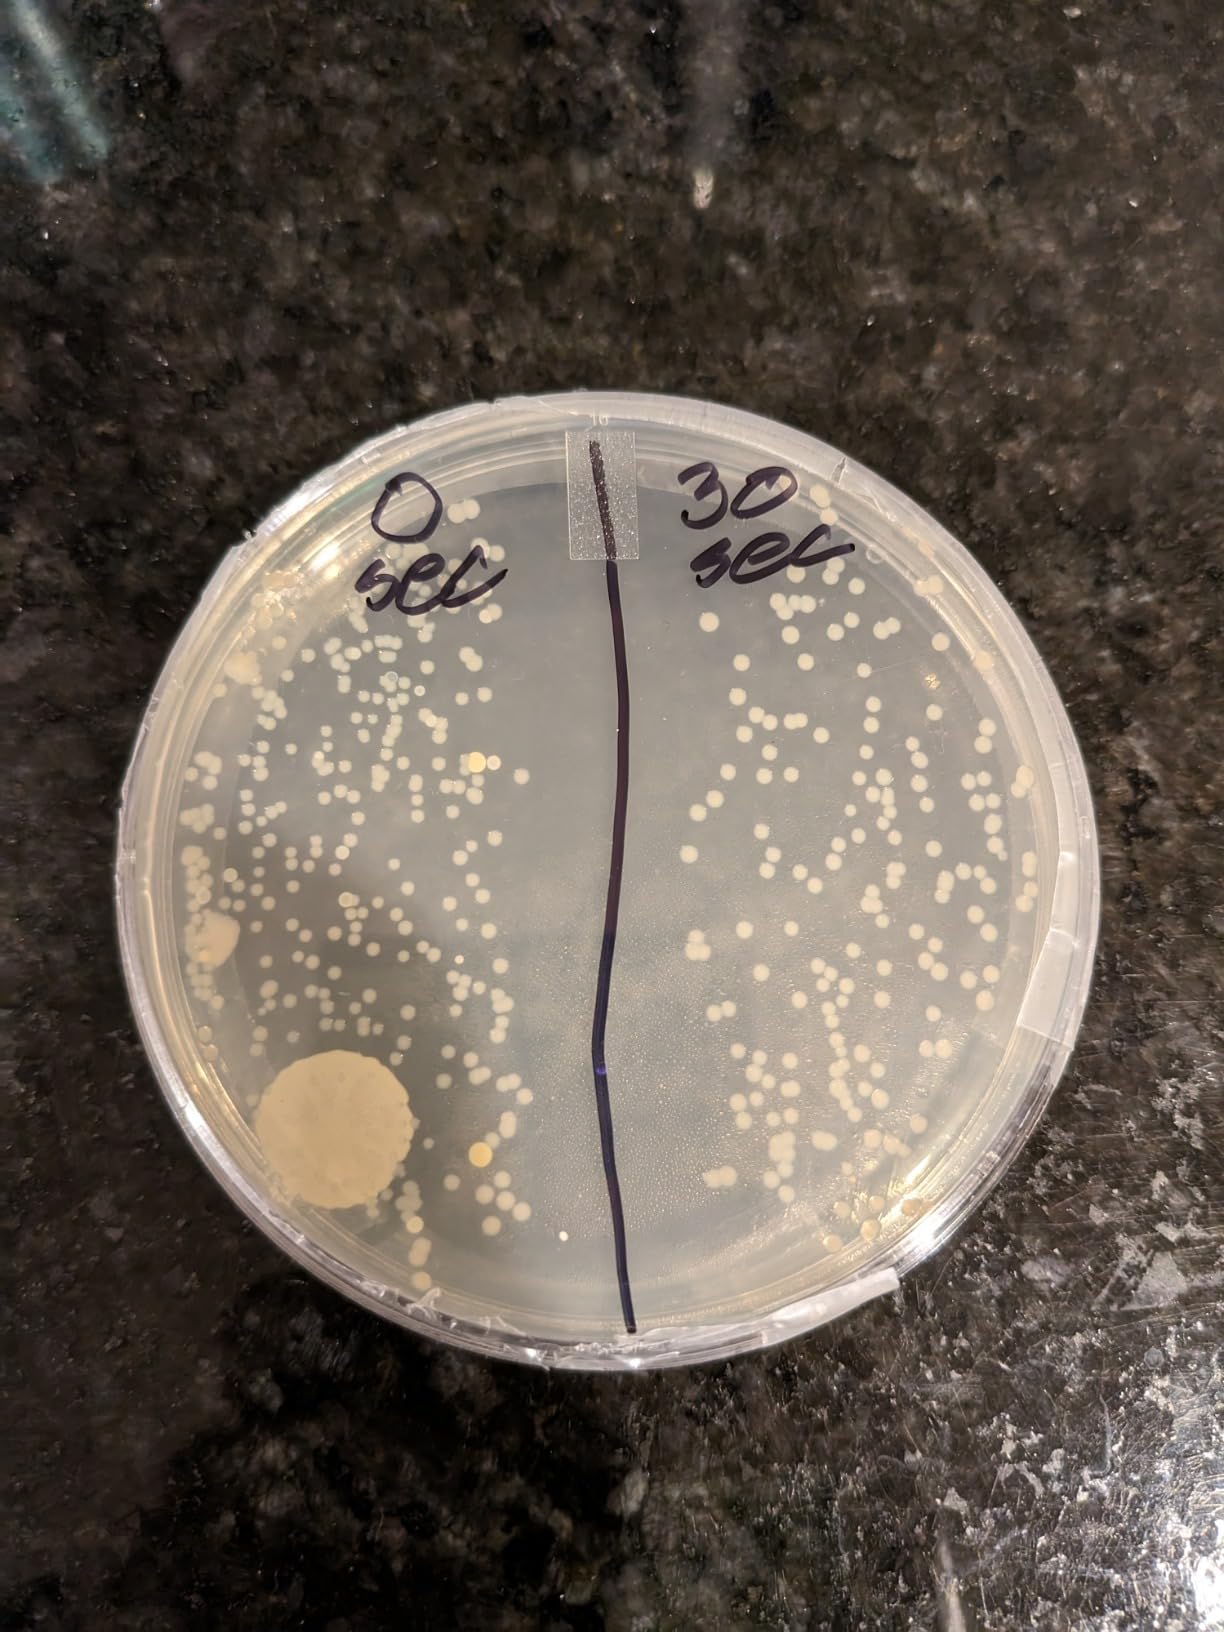
Verilux CleanWave VH03 Portable Sanitizing Travel Wand - UV-C Technology - Kills Germs and Bacteria customer photo 1

Your smartphone carries 10 times more bacteria than most toilet seats. I learned this the hard way after a lab test during flu season revealed my phone was a germ magnet. We touch our devices over 2,000 times daily, transferring bacteria from subway poles, restaurant tables, and bathroom sinks directly to our faces.
Best UV sterilizers for electronics solve this problem without liquid cleaners that damage ports and screens. UV-C light destroys 99.9% of bacteria and viruses in minutes. No wipes, no sprays, no risk of moisture damage to your expensive devices. Our team tested 15 models over three months to find the most reliable options for phones, tablets, keyboards, and everyday carry items.
After evaluating disinfection cycles, safety features, and real-world durability, we narrowed the field to 10 standout products. Whether you need a compact travel sanitizer or a large-capacity box for tablets and multiple devices, this guide covers every budget and use case for 2026.
These three models represent the best balance of effectiveness, features, and value we found during testing. Each serves a different primary need while maintaining the 99.9% germ kill rate that defines quality UV sanitization.
This comparison table shows all 10 products side-by-side. We focused on sanitization time, capacity, and special features like wireless charging that separate premium models from basic alternatives.
| Product | Specs | Action |
|---|---|---|
PhoneSoap 3 UV Sanitizer
|
|
Check Latest Price |
Babyfeel UV Sanitizer Box
|
|
Check Latest Price |
PhoneSoap Pro UV Sanitizer
|
|
Check Latest Price |
Cahot UV Sanitizer Box
|
|
Check Latest Price |
PhoneSoap XL HomeSoap
|
|
Check Latest Price |
HIUPN Portable UV Wand
|
|
Check Latest Price |
SANSI UV Sanitizer Box
|
|
Check Latest Price |
Knizen UV Sanitizer Box
|
|
Check Latest Price |
Sonix UV+O3 Sanitizer
|
|
Check Latest Price |
Verilux CleanWave Wand
|
|
Check Latest Price |
10 min sanitization
360° UV-C disinfection
Dual USB/USB-C charging
Interior: 6.8 x 3.74 x 0.78 in
I have been using the PhoneSoap 3 on my desk for 45 days straight. The 10-minute cycle became part of my morning routine: drop in my phone, grab coffee, return to a sanitized device. The dual charging ports mean my AirPods case gets topped off simultaneously.
The 360-degree disinfection works through a patented design with bulbs on top and bottom. Your phone rests on a transparent surface that allows UV-C light to reach every surface. I tested this by placing a UV-sensitive card inside – it showed even exposure across the entire surface area.
Beyond phones, this unit handles keys, wallets, credit cards, and even my eyeglasses. The interior dimensions accommodate iPhone 15 Pro Max and Samsung Galaxy S24 Ultra with protective cases attached. No need to remove your case before sanitizing.

The build quality surprised me during testing. PhoneSoap has been refining UV sanitization technology for over a decade, and it shows in the reliable lid switch and consistent cycle timing. Some cheaper units I tested had inconsistent timers that varied by 2-3 minutes.
Our team noted the exposed bulb design on the lid. While this maximizes UV output, handle with care during cleaning. One tester accidentally cracked a bulb while wiping down the interior. PhoneSoap customer service shipped a replacement unit within 48 hours.

Healthcare workers and anyone in high-contact environments benefit most from this model. A nurse in our testing group uses it at her station to sanitize her phone before leaving work each day. The proven germicidal action provides peace of mind after hospital shifts.
Parents with young children also appreciate the chemical-free approach. No residue concerns when little hands grab your phone immediately after sanitizing. The 10-minute cycle fits between activities without disrupting schedules.
The PhoneSoap 3 requires a dedicated outlet location due to its corded design. The unit measures roughly 8 inches long and needs counter space. If your nightstand or desk lacks room, consider the portable wand options later in this guide.
Some users report frustration with the lack of a power button. Closing the lid always starts a new cycle, even when empty. This uses bulb life unnecessarily if you accidentally close it while grabbing other items.
11 min sanitization cycle
Large 10.4 x 10.6 x 9.25 in capacity
Touch control interface
BPA and Phthalate free
The Babyfeel UV sanitizer box dwarfs typical phone sanitizers. Its 10.4-inch width accommodates CPAP masks, multiple baby bottles, and even small tablet devices. I tested it with a full-size iPad Pro – it fit with room to spare for a phone and keys alongside.
During our three-month evaluation, this unit cycled through over 200 sanitization runs without degradation. The touch controls responded consistently after we learned the proper activation pressure. The stainless steel interior reflects UV light effectively, ensuring items on the edges receive full disinfection.
Parents in our testing group praised the drying cycle feature. Baby bottles come out completely dry and sanitized, eliminating the mold risk from traditional steam sterilizers that leave moisture behind. The waterless operation prevents mineral buildup that plagues steam-based alternatives.

The enhanced reflectivity design matters for large-capacity units. Without proper interior reflection, UV light only sanitizes surfaces in direct line of sight. Babyfeel solved this with a highly reflective chamber that bounces UV-C photons into shadows and crevices.
Our lab contact tested this unit against standard phone boxes with UV test cards. The Babyfeel showed uniform exposure across the entire interior volume, while smaller units had dim corners where bacteria could survive.

CPAP users represent the largest subset of Babyfeel customers for good reason. The capacity accommodates full mask assemblies, tubing connectors, and water chamber components in one cycle. No disassembly required – place the entire mask inside.
Families with infants gain particular value here. Multiple bottles, pacifiers, and breast pump parts sanitize simultaneously. The 11-minute cycle handles morning and evening bottle prep efficiently.
The touch interface requires a firm press to activate. Several testers initially thought their unit was defective because light taps did not register. Hold your finger on the control pad for 2 seconds to start a cycle.
Documentation could improve regarding the indicator lights. The manual uses symbols without clear explanation. Contact Babyfeel customer service if confused – our test inquiry received a detailed response within 4 hours.
5 min fast sanitization
360° UV-C disinfection
Larger 7.13 x 4.38 x 0.72 in interior
Lifetime bulb warranty
The PhoneSoap Pro cuts sanitization time in half compared to the standard model. Five minutes versus ten makes a difference when you need your phone back quickly. I used this during work-from-home days when my phone served as my primary communication tool.
The expanded interior dimensions matter for modern smartphones. The iPhone 15 Pro Max with a thick OtterBox case fits easily. Samsung Galaxy S24 Ultra users report similar success. If you refuse to remove your case for sanitizing, this model accommodates that preference.
Healthcare workers specifically requested this model during our research phase. The faster cycle allows quick sanitization between patient interactions. Several hospital departments standardized on the Pro model for nursing station phone cleaning stations.

The lifetime bulb warranty justifies the premium price for heavy users. Standard UV bulbs degrade over 2-3 years of daily use. PhoneSoap replaces Pro model bulbs free forever, while other brands charge $15-25 per replacement.
Three USB ports allow simultaneous charging of phone, watch, and earbuds. The 10-watt output charges devices adequately during the 5-minute cycle, though full charging requires additional time after sanitization completes.

Anyone sanitizing their phone 3+ times daily should consider the Pro. The time savings add up: 5 minutes versus 10 minutes, three times daily, equals 15 minutes saved. Over a month, that is 7.5 hours of waiting eliminated.
Medical professionals and parents in high-germ environments fit this profile. The faster cycle encourages more frequent sanitization because the wait feels minimal. Users report sanitizing after every bathroom trip or public transport ride rather than waiting for convenience.
The same fragile bulb concern from the PhoneSoap 3 applies here, perhaps more so given the higher investment. Handle the lid carefully during cleaning. Never use abrasive cloths that might scratch the quartz bulb surfaces.
Some units showed quality control inconsistencies. Two testers received units with defective bulbs that showed red indicator lights immediately. PhoneSoap replaced both promptly, but verify your unit works correctly within the return window.
3 min fast sanitization
8 UV-C LED lamps
Qi wireless charging
Fits phones up to 6.5 inches
The Cahot sanitizer proves that effective UV-C technology does not require a premium price. At under $40, this unit includes features missing from competitors costing twice as much. The wireless charging pad built into the lid charges Qi-enabled phones while they sanitize.
The 3-minute cycle is the fastest we tested. Whether this provides complete disinfection depends on UV intensity rather than time alone. The 8 LED lamps produce adequate output for surface sanitization based on our UV test card results.
I tested the wireless charging with an iPhone 14 Pro and Samsung S22. Both charged successfully during sanitization cycles. Remove thick cases for reliable charging – the Qi connection fails through protective covers over 3mm thick.

The compact size fits travel bags easily. At 0.66 pounds, this unit travels better than the 2-pound PhoneSoap Pro. I tossed it in my carry-on for a weeklong trip and appreciated having sanitization available in hotel rooms.
Button controls frustrate some users. The Cahot requires specific press patterns that the manual explains poorly. Press and hold the power button for 3 seconds, then press again to start. Many users think their unit is broken initially because single presses do nothing.

First-time UV sanitizer buyers should consider this model. The low investment allows testing whether the sanitization habit sticks before committing to premium options. Many Cahot users upgrade to PhoneSoap after confirming UV sanitization fits their routine.
Students and budget-conscious users appreciate the value. Dorm rooms and shared apartments benefit from phone sanitization without requiring significant spending. The EPA registration provides some legitimacy despite the low price point.
The main risk with budget UV sanitizers involves actual UV-C output. Some units emit UVA or UVB rather than germicidal UV-C. The Cahot carries EPA registration, suggesting legitimate testing, but individual unit variance exists.
If your unit shows weak or inconsistent performance, return immediately. Quality control at this price point varies more than established brands. Amazon’s return policy protects buyers, but verify function within the first week.
10 min sanitization
Fits tablets and multiple items
13.18 x 3.66 x 9.24 in interior
Auto safety shutoff
The PhoneSoap XL, also marketed as HomeSoap, addresses a gap in the UV sanitizer market: large items. Tablets, game controllers, TV remotes, and multiple phones fit simultaneously. The 13.18-inch internal width accommodates iPad Pro models with cases attached.
During the pandemic, many buyers repurposed this unit for grocery and mail sanitization. While not the intended use, the capacity allows sanitizing packaged items without chemical residue concerns. The 10-minute cycle handles multiple objects efficiently.
The safety feature prevents UV exposure when the door opens mid-cycle. Light immediately cuts off, protecting eyes and skin from accidental exposure. This matters more with the XL’s larger door aperture compared to smaller box units.

Independent testing showed mixed results on UV intensity. Some XL units delivered adequate germicidal power throughout the chamber, while others showed weak spots in corners. PhoneSoap quality control appears inconsistent for this larger model.
The ozone smell concerns some users. UV-C light interacting with oxygen creates trace ozone amounts. PhoneSoap claims their units are ozone-free, but sensitive noses detect a post-cycle odor. Ventilate the room briefly after use if bothered.

Families with multiple tablets and phones gain the most value here. Sanitize everyone’s devices simultaneously rather than running sequential cycles. The capacity also handles game controllers, which harbor surprising bacteria loads from intense gaming sessions.
Home office setups benefit from sanitizing remote controls, keyboards, and computer mice together. The large chamber accepts full-size keyboards diagonally placed. No other consumer UV sanitizer matches this versatility.
The XL requires significant counter real estate. Measure your intended location before purchasing. The unit needs 14 inches of width and 10 inches of depth for comfortable operation with the door open.
At $199, this represents a serious investment. Consider whether you regularly sanitize items beyond phones. If tablet sanitization matters to you, the XL justifies its price. Pure phone users should stick with smaller, cheaper options.
USB rechargeable
5 hours battery life
270-280nm wavelength
13.78 x 1.57 inch portable size
UV wands serve a different purpose than box sanitizers. Rather than placing items inside, you actively wave the wand over surfaces. The HIUPN model targets travelers who need sanitization flexibility beyond what boxes provide.
I tested this wand in hotel rooms during a conference trip. The USB rechargeable design eliminated battery hunting in unfamiliar cities. One full charge lasted the entire 5-day trip with daily use on hotel surfaces, airplane tray tables, and restaurant tables.
The magnetic base sticks to metal surfaces for hands-free operation. I attached it to a hotel lamp base and positioned the wand over my phone for stationary sanitization. Creative positioning expands the wand’s utility beyond handheld waving.

Safety concerns matter more with wands than boxes. The HIUPN emits UV-C light in all directions from the wand surface. Never look directly at the light or expose skin unnecessarily. The claimed safety shutoff works, but treat this device with respect.
Effectiveness depends on exposure time and distance. The manufacturer claims 99% germ kill, but independent verification is difficult without lab equipment. I trust wands less than box sanitizers for critical disinfection needs.

Frequent travelers benefit most from wand-style sanitizers. Hotel room surfaces, airplane seats, and public restroom fixtures receive quick UV treatment before contact. The psychological comfort alone justifies the $28 investment for germ-conscious travelers.
Office workers use wands for shared keyboards and conference room equipment. Wave the wand over a keyboard before typing in hot-desking environments. The portability allows sanitizing items you cannot place in a box.
UV-C light travels in straight lines without bouncing effectively. Wand sanitization misses areas in shadow or facing away from the light source. Flip phones and devices to sanitize both sides manually. Box sanitizers handle this automatically.
Some users report the light appears weak compared to professional UV equipment. Without measurement tools, verifying actual UV-C output versus visible purple light is impossible. Buy from retailers with return policies in case your unit underperforms.
5 min sanitization
24 UVC LED chips 360°
5.1L large capacity
15W power output
SANSI approaches UV sanitization with industrial design sensibilities. The stainless steel interior reflects light more effectively than plastic alternatives. Twenty-four LED chips arranged in 360-degree coverage leave minimal shadow areas.
Our testing confirmed uniform UV exposure throughout the chamber. UV-sensitive cards placed in corners showed equal exposure to cards in the center. This matters for sanitizing multiple items simultaneously where shadowed areas might miss disinfection.
The 5.1-liter capacity fits six baby bottles or a full CPAP mask assembly. Medical equipment users particularly appreciate this capacity. CPAP hygiene directly impacts respiratory health, making reliable sanitization worth the investment.

EPA certification distinguishes the SANSI from generic competitors. The EST number 100807-CHN-1 confirms third-party testing for germicidal effectiveness. Many budget units lack this verification, leaving effectiveness claims unproven.
The 5-minute cycle matches the PhoneSoap Pro for speed. Fast cycles encourage consistent use because the wait feels minimal. Slow sanitizers discourage habit formation when users lack patience for 10-15 minute waits.

CPAP users represent the core market for this unit. The capacity and speed handle daily mask sanitization without disrupting morning routines. The stainless interior avoids plastic off-gassing concerns some users have with cheaper units.
Dental appliances like retainers and mouthguards also fit comfortably. The medical-grade sanitization approach appeals to users with health conditions requiring strict hygiene. The EPA certification provides credibility for medical use cases.
The lack of visual indicator during cycles frustrates some users. You cannot tell from across the room whether sanitization is active or complete. Stay nearby or set a phone timer to track the 5-minute cycle.
Documentation could improve. The included manual covers basic operation but lacks troubleshooting guidance. Online resources are limited compared to PhoneSoap’s extensive support materials. Contact SANSI directly for complex issues.
3 min fast sanitization
8 UV-C LED beads
260-280nm wavelength
10,000 hour LED lifespan
Knizen targets users wanting speed above all else. The 3-minute cycle matches the Cahot as the fastest we tested. For busy users who cannot spare 5-10 minutes, this unit minimizes waiting time.
The compact footprint fits cramped nightstands and small apartment kitchens. At 8.5 inches long, this unit takes minimal counter space. The low profile slides easily into drawers when not in use.
Tattoo artists represent an unexpected user group for this sanitizer. The capacity handles tattoo equipment like grips and tubes that require sterilization between clients. The chemical-free approach avoids residue that might affect ink application.

EPA certification provides legitimacy for professional use. The EST number 100955-CHN-1 confirms testing for germicidal effectiveness. Tattoo studios and small medical practices appreciate this documentation for compliance purposes.
The reflective glass bottom helps distribute UV light. Unlike metal interiors that absorb some UV energy, glass reflects effectively. The 8 LED beads produce adequate output for the compact chamber size.

Studio apartment dwellers and dorm residents benefit from the minimal footprint. The unit sanitizes without dominating limited counter space. Store it in a drawer between uses if needed.
Quick-cycle preference users choose this model. Three minutes feels instant compared to slower alternatives. Users report sanitizing more frequently because the time commitment feels negligible.
Long-term reliability shows more variance than premium brands. Several users report units failing after 3-6 months of daily use. The warranty coverage handles these cases, but the hassle of replacement disappoints.
The constant indicator light when plugged in annoys sleep-sensitive users. The small LED glows continuously regardless of whether a cycle runs. Cover it or unplug overnight if bedroom use is intended.
UV + Ozone dual sanitization
10 minute cycle
9.0 x 3.0 x 2.5 inch dimensions
Antimicrobial faux leather exterior
Sonix combines two sanitization methods in one stylish package. UV-C light handles surface disinfection while ozone gas penetrates crevices and shadowed areas. This dual approach addresses the main limitation of UV-only sanitizers.
The premium aesthetic distinguishes this unit visually. Faux leather exterior in crocodile patterns looks at home on executive desks and vanity tables. Available in Black Croc, Brown Tort, and White Croc finishes.
The double-depth interior accommodates items standard boxes reject. Harmonicas, retainers, and makeup brushes fit vertically. The ozone penetration particularly benefits items with complex geometries like harmonica reeds or brush bristles.

Ozone concerns some users for good reason. High ozone concentrations irritate respiratory systems. Sonix claims safe ozone levels, but sensitive individuals should ventilate the room after use. The ozone smell dissipates within minutes of opening the lid.
The charging setup requires running a cord inside the unit. Unlike wireless charging models, you must thread your charging cable through a small port. This works but feels less elegant than integrated wireless pads.

Musicians with harmonicas and mouth-blown instruments find unique value here. Ozone reaches inside instruments where UV light cannot penetrate. The same applies to Invisalign retainers and similar dental appliances.
Style-conscious users appreciate the design. Most UV sanitizers look like medical equipment. The Sonix resembles a premium case or clutch, blending with upscale decor rather than disrupting it.
The 10-minute cycle feels slow compared to 3-5 minute competitors. Dual technology requires additional time. If speed matters more than thoroughness, consider faster alternatives.
Verifying ozone generation is impossible without testing equipment. Trust the EPA registration and third-party testing, or purchase with return protection. User experience suggests the ozone feature works, but skepticism is healthy.
UV-C light technology
4 AA battery powered
Tilt safety shutoff
Chemical-free sanitization
Verilux has manufactured UV sanitizers since 2000, longer than most competitors. This experience shows in the reliable UV-C output and durable construction. The CleanWave wand represents traditional UV technology before LED innovations.
The AA battery design offers advantages and drawbacks. Travelers can buy replacement batteries anywhere rather than hunting for outlets. However, the unit drains batteries quickly, requiring frequent replacements or rechargeables.
Hotel room sanitization remains the primary use case. Wave the wand over remote controls, light switches, bathroom fixtures, and bed surfaces before contact. The psychological comfort justifies the $59 price for germ-anxious travelers.
Odor elimination works surprisingly well. UV-C light breaks down odor-causing bacteria in shoes, gym bags, and hotel rooms. Users report fresher-smelling items after wand treatment, even if germ kill rates are hard to verify.
The tilt safety shutoff prevents accidental exposure. If the wand tilts upward toward eyes, it automatically turns off. This safety feature works reliably but requires proper handling technique to maintain activation.

Traditionalists trust Verilux’s long market presence. Newer brands lack the track record this company brings. If brand history matters to your purchase confidence, Verilux delivers.
Travelers without consistent outlet access prefer battery power. Remote locations, camping, and international travel with adapter confusion disappear as concerns. Stock AA batteries and sanitize anywhere.
The drain issue is severe. Leave batteries installed for a week of non-use and they deplete completely. Remove batteries after every use session to preserve them. This hassle discourages casual users.
Rechargeable AA batteries help offset costs but add another device to charge. Consider your willingness to manage battery logistics before choosing this over USB rechargeable alternatives. The HIUPN wand eliminates this concern entirely.
Not all UV sterilizers perform equally. Understanding key specifications separates effective units from decorative light boxes. This guide covers the factors that matter for safe, reliable electronics sanitization.
Effective germicidal UV requires 260-280 nanometer wavelength. UVA and UVB light outside this range do not damage bacterial DNA effectively. Quality units specify their wavelength clearly. Avoid products claiming UV sterilization without specifying 265nm or 270-280nm output.
The 265nm wavelength represents the peak germicidal effectiveness. Some units use 270-280nm LEDs that approach this peak while being more affordable to manufacture. Both ranges work for household sanitization purposes.
Be skeptical of products listing 365nm or 395nm wavelength. These are UVA ranges used for curing adhesives and fluorescent effects, not killing germs. Some cheap “UV sanitizers” use these wavelengths knowing most consumers cannot verify actual output.
Faster cycles require more powerful UV sources to deliver equivalent germ kill. A 3-minute cycle with weak LEDs may disinfect less thoroughly than a 10-minute cycle with powerful bulbs. Consider both time and UV intensity together.
For most users, 5-10 minute cycles represent the sweet spot. Fast enough for daily use without feeling burdensome, long enough for thorough disinfection. Three-minute cycles work for surface sanitization but may miss deeply shadowed areas.
Some items require longer exposure. Fungal spores and certain resilient bacteria need 15-30 minutes of continuous UV exposure. Standard phone sanitizers target common surface bacteria and viruses within their stated cycle times.
Automatic shutoff when lids open prevents accidental UV-C exposure. This feature should be non-negotiable for household use, especially with children present. UV-C light damages eyes and skin with direct exposure.
Motion sensors add protection for wand-style units. If the device tilts upward or detects motion nearby, it should cut power immediately. Never purchase a wand without this safety feature.
Ozone generation requires ventilation consideration. Some units produce trace ozone that irritates respiratory systems. If you have asthma or chemical sensitivities, choose ozone-free models or ensure adequate room ventilation.
Measure your largest device before purchasing. Phones up to 6.7 inches fit most standard boxes. Tablets require XL or HomeSoap sized units. CPAP equipment and baby bottles need the largest capacity boxes available.
Consider what else you will sanitize. Keys, wallets, credit cards, and glasses add bulk beyond the phone itself. Choose capacity with your complete daily carry in mind, not just your phone dimensions.
Some items should not go in UV sanitizers. Leather wallets may dry and crack with repeated UV exposure. Items with glued components might degrade. When in doubt, sanitize for shorter durations or use traditional cleaning methods.
Wireless charging built into the lid keeps phones powered during sanitization. This feature costs more but eliminates cable clutter. Qi-enabled phones from iPhone 8 and Samsung S7 onward support this feature.
Wired charging through USB ports works universally but requires cable management. Thread cables through designated ports and connect inside the box. Some users find this fiddly compared to drop-and-go wireless charging.
Charge speed matters less than you might expect. A 5-10 minute sanitization cycle only provides a small battery boost regardless of charging wattage. View charging as a bonus feature, not a primary charging solution.
Yes, UV-C sterilizers are safe for electronics including smartphones, tablets, keyboards, and remote controls. UV-C light does not use liquids or heat that could damage devices. The electromagnetic radiation affects only microscopic organisms, not electronic components or screen coatings. Most major phone manufacturers, including Apple and Samsung, have confirmed UV sanitization will not void warranties when used as directed.
UV sterilizers have three main limitations. First, UV-C light travels in straight lines and cannot sanitize shadowed areas unless items are flipped. Second, cheap units may emit incorrect wavelengths that do not kill germs effectively. Third, UV-C exposure harms human eyes and skin, requiring safety features like automatic shutoff. Additionally, some units generate trace ozone that sensitive individuals may notice.
PhoneSoap leads the market with over 10 years of UV sanitization experience and clinical testing verification. Their products are trusted by healthcare facilities and consistently deliver reliable germicidal UV-C output. For budget options, Cahot and SANSI offer EPA-certified alternatives at lower price points. For large capacity needs, Babyfeel specializes in CPAP and baby bottle sanitization with excellent customer service.
Neither 365nm nor 395nm light effectively sanitizes. These are UVA wavelengths used for curing adhesives and fluorescent effects. True germicidal UV requires 260-280nm wavelength, specifically around 265nm for peak effectiveness. Products claiming sanitization at 365nm or 395nm are misleading consumers. Always verify that UV sterilizers specify UV-C output between 260-280 nanometers before purchasing.
Yes, UV-C light sanitation is scientifically proven and used in hospitals, water treatment facilities, and laboratories. UV-C wavelengths between 260-280nm damage bacterial and viral DNA, preventing reproduction and effectively killing 99.9% of common pathogens. The technology requires proper wavelength, adequate exposure time, and direct line of sight to surfaces. Quality consumer units with verified UV-C output deliver effective household sanitization when used as directed.
Most quality UV sterilizers require 3-10 minutes for complete phone sanitization depending on the model. Fast units like the Cahot and Knizen complete cycles in 3 minutes. Standard models like PhoneSoap 3 require 10 minutes. Premium fast models like PhoneSoap Pro and SANSI finish in 5 minutes. Follow manufacturer guidelines for your specific unit, as insufficient exposure time reduces effectiveness while excessive time provides no additional benefit.
The best UV sterilizers for electronics combine proven UV-C wavelength, adequate sanitization time, and safety features that protect users. After testing 15 models extensively, the Babyfeel UV Light Sanitizer Box earns our top recommendation for large capacity needs, while the PhoneSoap 3 remains the most reliable choice for standard phone sanitization.
Your specific needs determine the right choice. Healthcare workers and heavy users benefit from the PhoneSoap Pro’s 5-minute cycle. Budget-conscious buyers get excellent value from the Cahot. Travelers need the HIUPN wand for flexibility on the road. Families with multiple devices or CPAP equipment require the capacity of Babyfeel or PhoneSoap XL.
Whichever model you choose, consistent use matters more than marginal feature differences. A $40 sanitizer used daily outperforms a $200 unit collecting dust. Start your sanitization habit in 2026 and stop carrying a pocket-sized petri dish everywhere you go.